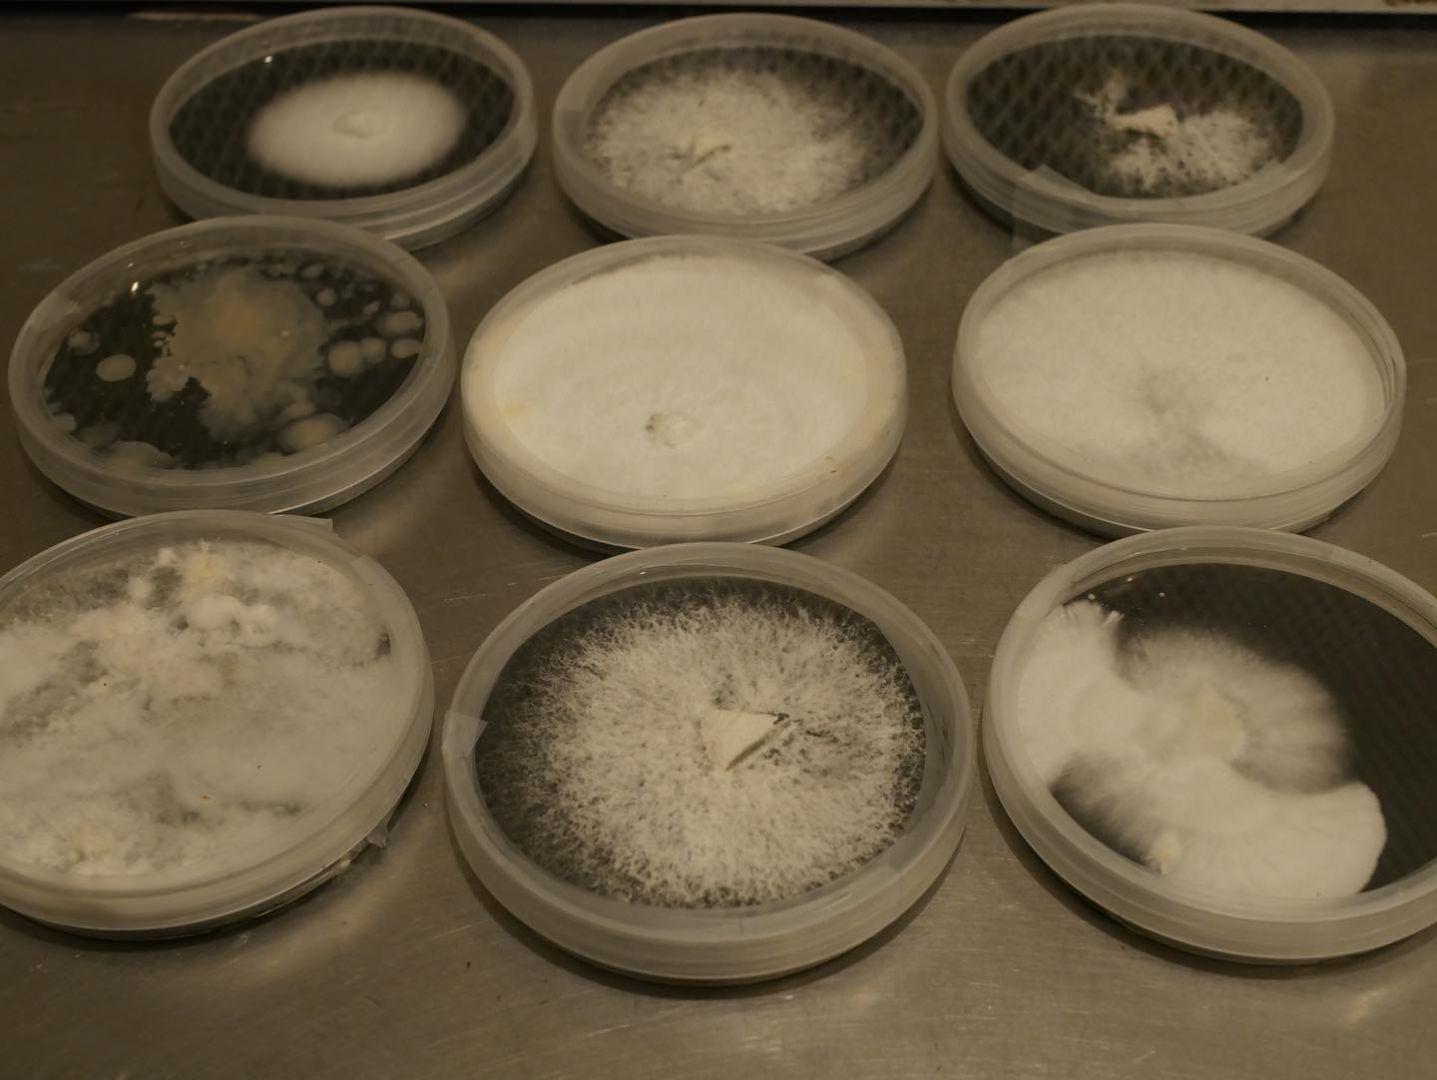
image 5

Mushroom Farm Tour + Mushroom Harvesting (Age 8+)
Event booking
5 Mar 2025
Event time
10:00 AM-11:30 AM
10
🚩 This occurrence ended - more dates below
Tours
Buda, Texas
0.0 (0 Reviews)
OverviewLocation
Metropolitan area
Features
4.50 · 10 reviews
Overall rating
5
4
3
2
1
Educational Value
4.5
Enjoyable Experience
4.6
Description Accuracy
4.7
Value for Price
4.8
Similar Experiences
8 events available for you. View All
Newsletter
Stay updated with the latest news, events, products & more! 🌱
Whether you’re looking for activities to do with your kids, novel dates, or retiree roadtrip ideas, our newsletters keep you in the loop